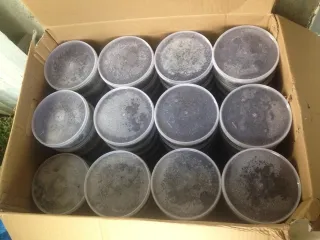
За экологическое преступление пойдут под суд шесть мужчин в Хабаровском крае

В Хабаровске завершено расследование уголовного дела в отношении шестерых мужчин, обвиняемых в совершении преступления, предусмотренного ч. 3 ст. 258.1 УК РФ (незаконный оборот особо ценных водных биологических ресурсов, принадлежащих к видам, занесенным в Красную книгу РФ и охраняемым международными договорами РФ, их частей и дериватов (производных). Их дело будет рассмотрено в суде, сообщает LIVE Биробиджан.
23 мая 2020 года на автодороге рядом с селом Константиновка Хабаровского района сотрудниками правоохранительных задержан легковой автомобиль, в салоне которого находились 250 килограммов икры рыб осетровых видов. По данному факту возбуждено уголовное дело. Водитель и пассажир задержаны.
В ходе следствия установлено, что злоумышленники приобрели икру у браконьеров в селе Софийск Ульчского района. Часть нелегального деликатеса они приобрели у участников преступной группы, состоящей из 4 человек. По ходатайству следствия в отношении всех шестерых обвиняемых избиралась мера пресечения в виде заключения под стражу.
Следствием собрана достаточная доказательственная база, в связи с чем уголовное дело передано для утверждения обвинительного заключения и дальнейшего направления в суд для рассмотрения по существу.
Источник - Следственным комитетом РФ и по Хабаровскому краю и ЕАО.
ССЫЛКИ ПО ТЕМЕ:
Дороже золота: Рост цен на дальневосточный деликатес прогнозирует эксперт
Взятку 5 млн предлагал полицейским браконьер в Хабаровском крае